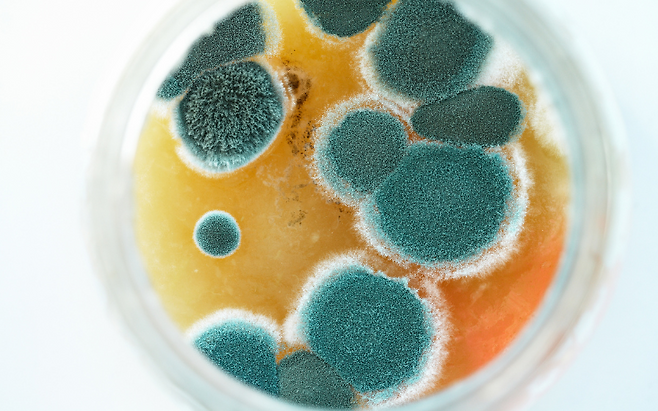

설거지 후 물컵, 어떻게 보관하고 계신가요?
대부분 위생을 위해 컵을 거꾸로 뒤집어 놓곤 합니다. 하지만 이 방식이 오히려 곰팡이와 세균을 키우는 주범이 될 수 있다는 사실, 알고 계셨나요? 잘못된 습관 하나가 가족 건강을 위협할 수 있습니다.
컵 안쪽에 습기·곰팡이균이 갇힙니다

컵을 거꾸로 놓으면 내부에 남은 수분이 빠져나가지 못하고 그대로 고입니다. 특히 컵과 선반 사이에 공기 순환이 잘 되지 않으면 어두운 틈새에 습기가 차면서 곰팡이균이 번식하기 좋은 환경이 만들어집니다.
육안으로 잘 보이지 않아도 바닥 면에 곰팡이 포자가 퍼질 수 있으며, 그대로 사용 시 입을 통해 몸속으로 들어갈 수 있습니다.
곰팡이와 세균은 위장·호흡기 건강에 악영향을 줍니다
컵 바닥에 생긴 곰팡이와 세균은 장내 염증을 유발하거나 면역력을 떨어뜨릴 수 있습니다. 특히 어린이나 노약자는 곰팡이에 더 민감해 복통, 설사, 기침 등의 증상이 반복될 수 있습니다. 위생을 위해 뒤집어 둔 행동이 오히려 병원에 가야 할 이유가 되는 셈입니다.
물기 제거 후 ‘입구 위로’ 보관하세요

가장 안전한 보관법은 깨끗이 세척한 후 마른 행주로 물기를 닦고, 입구가 위로 향하게 보관하는 것입니다. 바닥면에 통풍이 잘 되도록 수저통이나 건조대를 활용하는 것도 좋습니다. 컵을 포개거나 겹쳐두는 방식도 통기성이 떨어져 세균 증식을 유도할 수 있어 피해야 합니다.

매일 마시는 물, 사용하는 컵 하나에도 건강은 달려 있습니다. 컵을 거꾸로 놓는 습관이 입으로 곰팡이를 들이는 일이라는 사실을 기억해야 합니다. 오늘부터라도 보관 방식을 바꿔보세요. 단순한 습관 교정만으로도 가족 건강을 지킬 수 있습니다.
Copyright © 뇌생각